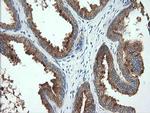
TMPRSS5 Antibody in Immunohistochemistry (Paraffin) (IHC (P))

Search
OriGene
TMPRSS5 Monoclonal Antibody (OTI4G4), TrueMAB™
{{$productOrderCtrl.translations['antibody.pdp.commerceCard.promotion.promotions']}}
{{$productOrderCtrl.translations['antibody.pdp.commerceCard.promotion.viewpromo']}}
{{$productOrderCtrl.translations['antibody.pdp.commerceCard.promotion.promocode']}}: {{promo.promoCode}} {{promo.promoTitle}} {{promo.promoDescription}}. {{$productOrderCtrl.translations['antibody.pdp.commerceCard.promotion.learnmore']}}
产品信息
TA504339
种属反应
宿主/亚型
分类
类型
克隆号
抗原
偶联物
形式
浓度
规格
纯化类型
保存液
内含物
保存条件
运输条件
靶标信息
Spinesin, also known as Serine protease 22 (PRSS22), is a gene located on chromosome 16p11.2 that encodes a trypsin-like serine protease predominantly expressed in the brain and airway tissues. This protease is part of the large family of serine proteases, characterized by their involvement in a variety of physiological processes, including digestion, immune response, and cellular remodeling. In the nervous system, Spinesin is implicated in synaptic function and plasticity, with potential roles in modulating neural connectivity and communication. It is also involved in processing extracellular matrix components, which can influence cell adhesion and migration, contributing to tissue remodeling and repair processes. Dysregulation of Spinesin expression or activity may impact neural development and has been associated with certain neurological disorders. Research into Spinesin continues to explore its specific functions in the nervous system and its potential therapeutic applications in neurobiology and regenerative medicine.
仅用于科研。不用于诊断过程。未经明确授权不得转售。
篇参考文献 (0)
生物信息学
蛋白别名: MGC141886; MGC148044; Spinesin; Transmembrane protease serine 5; transmembrane protease, serine 5; unnamed protein product
基因别名: SPINESIN; TMPRSS5
UniProt ID: (Human) Q9H3S3
Entrez Gene ID: (Human) 80975